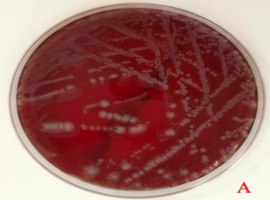
First Case Isolated of Kerstersia gyiorum from Purulent Ear Discharge in North Africa: Case Report

Soumaya El Bardouni1,2*, Chaimaa Myatt1,2, Reda Amrani Souhli1,2 and Karima Rissoul1,2
1Microbiology Laboratory, Mohammed VI University Hospital Center, Tangier, Morocco
2Microbiology Department, Faculty of Medicine and Pharmacy, Abdelmalek Essaadi University, Tangier, Morocco
*Corresponding author: Soumaya El Bardouni, Microbiology Laboratory, Mohammed VI University Hospital Center, Tangier, Morocco.
E-mail: soumayabardouni@gmail.com
Received: March 19, 2026; Accepted: April 03, 2026; Published: April 15, 2026
Citation: El Bardouni S, Myatt C, Souhli RA, et al. First Case Isolated of Kerstersia gyiorum from Purulent Ear Discharge in North Africa: Case Report. Clin Image Case Rep J. 2026; 8(2): 584.